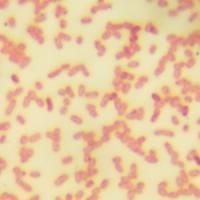
青色链霉菌

霉菌无菌试验培养基灵敏度试验法
互联网
1691
1 菌种
白色念珠菌、腊叶芽枝霉,由中国药品生物制品检定所分发。
2 培养基
凡应用于霉菌无菌试验用的培养基都应进行灵敏度试验。
3 操作
3.1 操作霉菌的无菌室应与其他无菌室隔离,有2个以上菌株试验时,不应在同一无菌操作室内同时进行。
3.2 将菌接种在土豆培养基上,20~25℃培养5~7天后用灭菌生理盐水洗下菌苔,移入装有玻璃珠的大管中将孢子打散,经装有脱脂棉注射器过滤。将菌液稀释至与标准比浊管相同之浓度,然后做10倍系列稀释。
3.3 将10-5~10-7菌液各1ml分别接种到9ml试验培养基中,每个稀释度至少接种3管并用未接种过的培养基作对照,20~25℃培育5天,逐日观察结果。
4 结果判定
以接种培养基管数的2/3以上呈现生长的最高稀释度为该培养基的灵敏度,3次试验中以2次达到的最高灵敏度为判定标准。